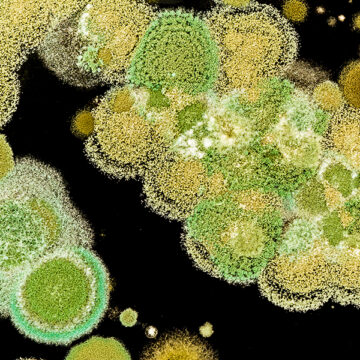

La pandemia ha peggiorato le abitudini alimentari
Roberta Lazzarini
In aumento lo spreco di cibo, soprattutto frutta e verdura. Manca un’educazione alla nutrizione che è la prima prevenzione per avere una buona salute.